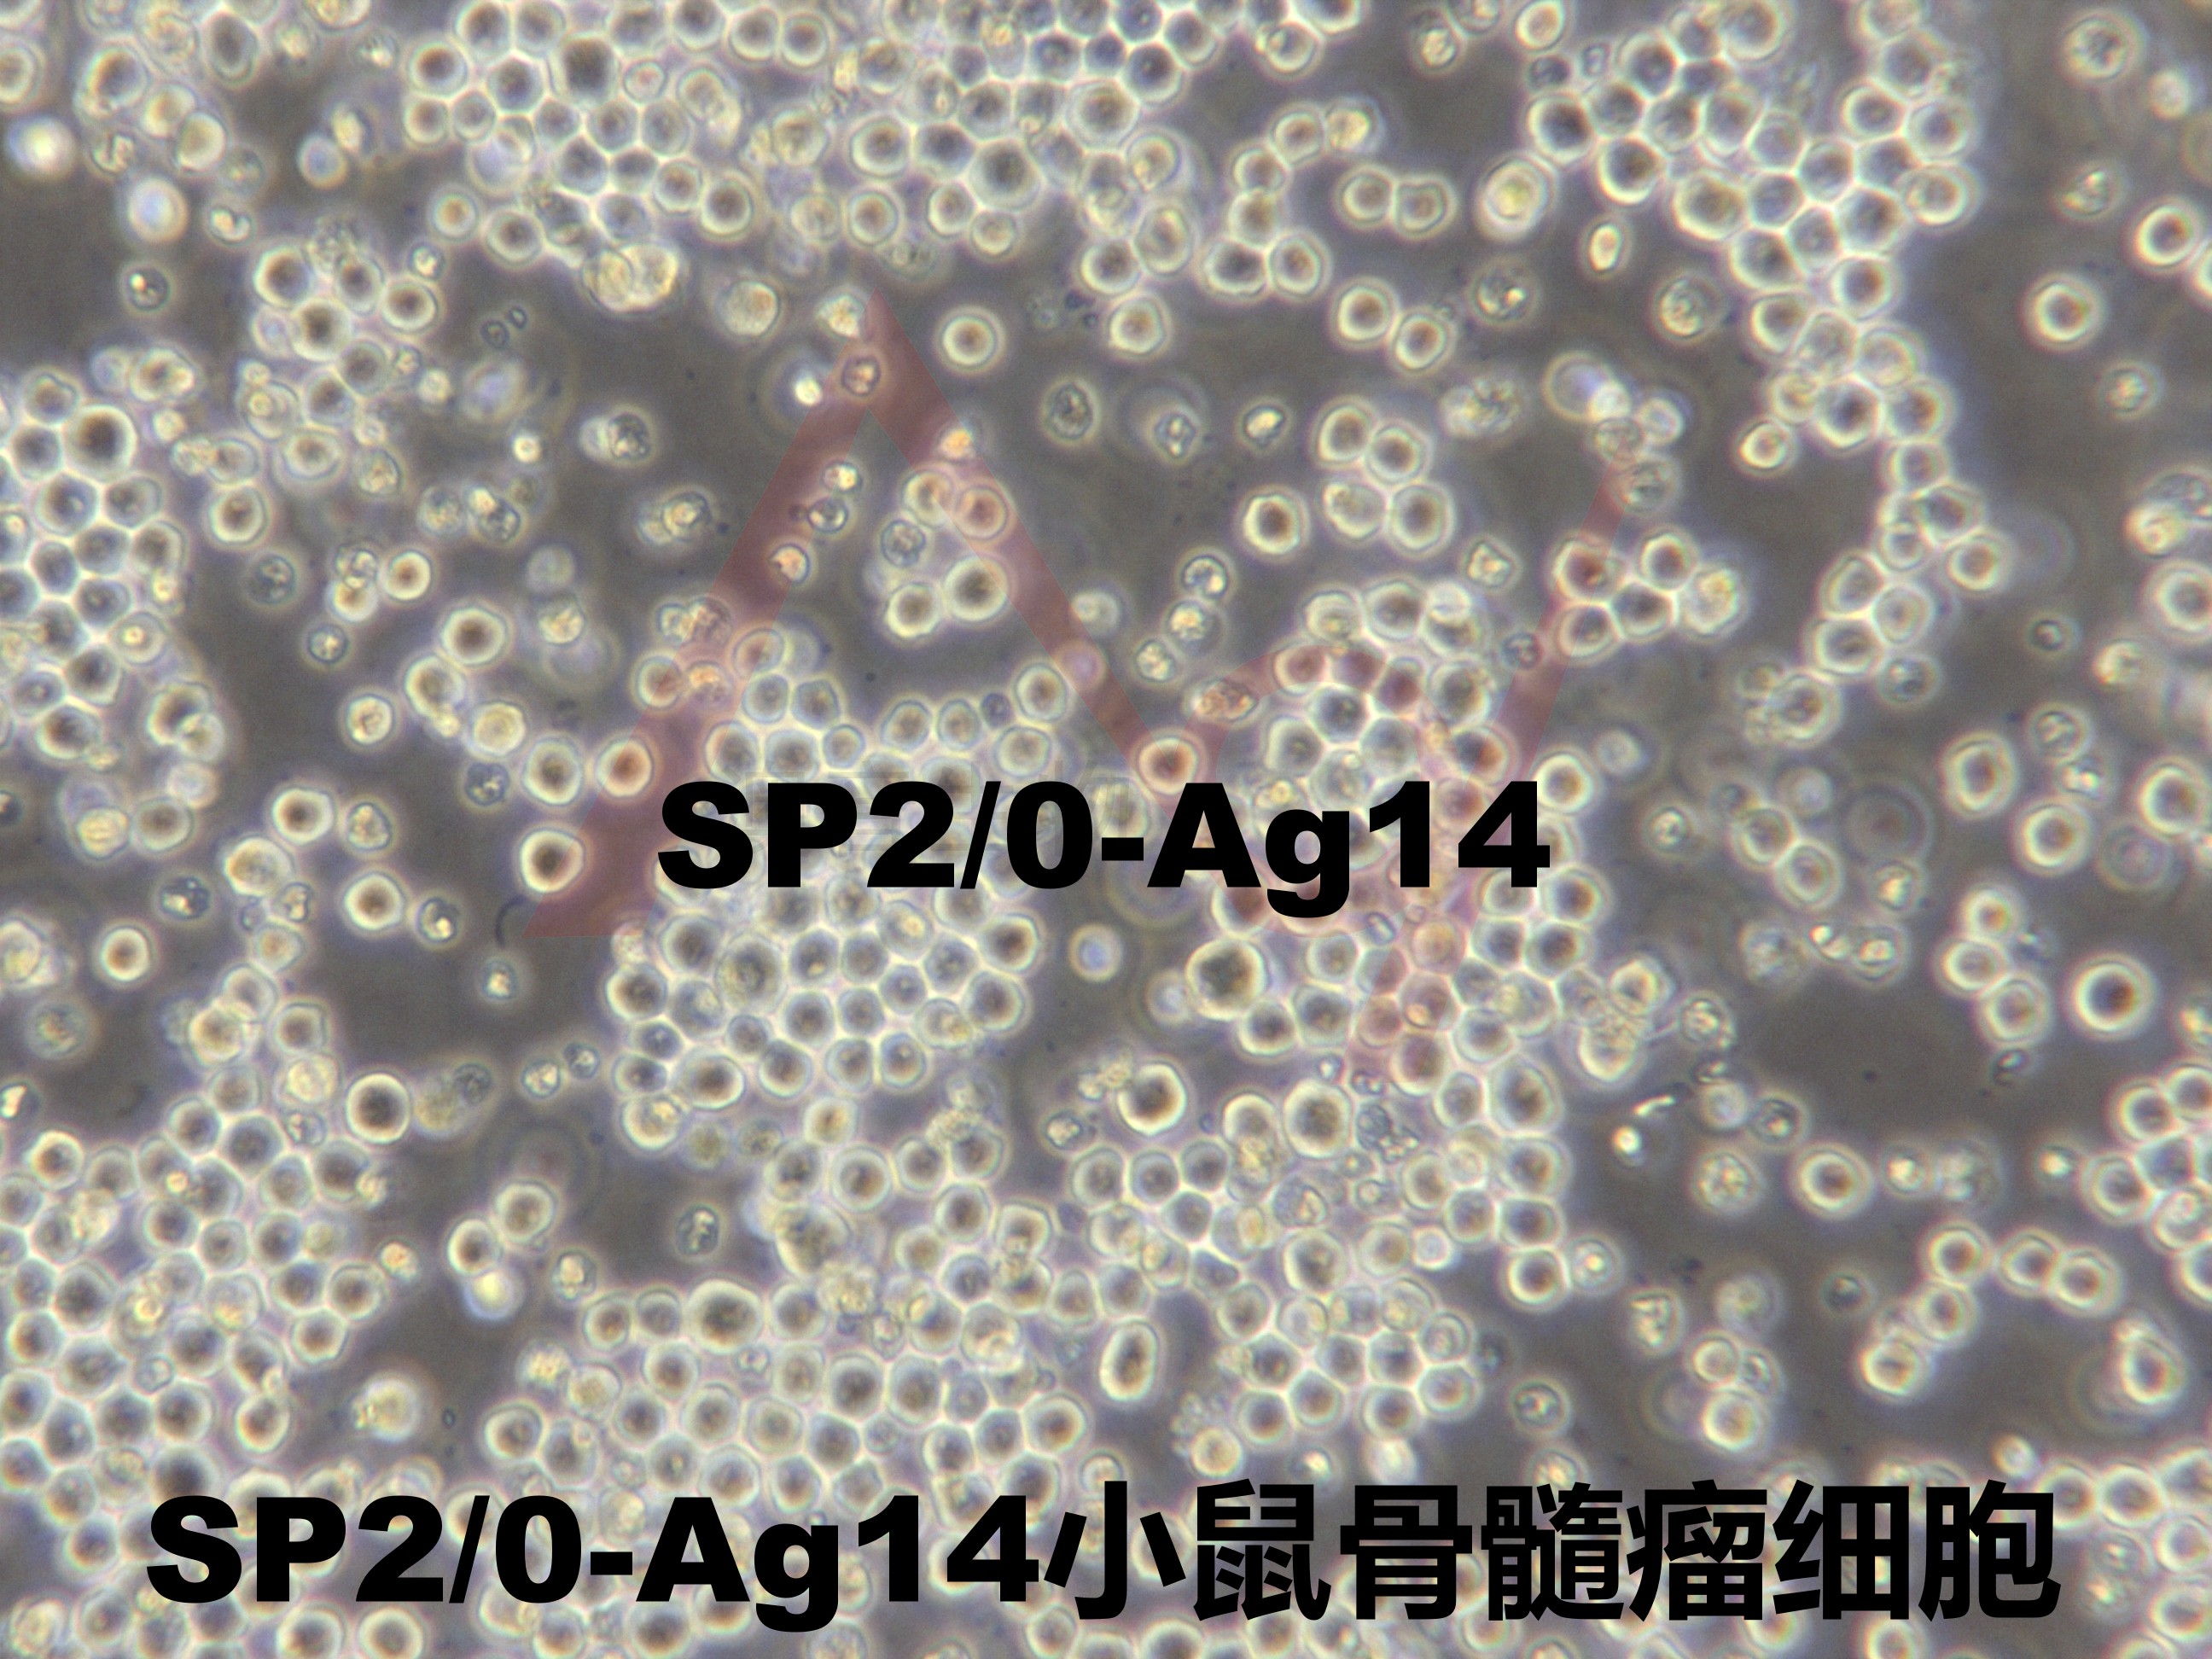
产品封面图

相关产品推荐更多 >
万千商家帮你免费找货
0 人在求购买到急需产品
- 详细信息
- 询价记录
- 文献和实验
- 技术资料
- 英文名:
Sp2/0-Ag14
- 库存:
1×10^6
- 供应商:
中科院
- 肿瘤类型:
--
- 细胞类型:
B淋巴细胞
- 品系:
BALB/c
- 组织来源:
脾脏
- 相关疾病:
骨髓瘤
- 物种来源:
小鼠
- 免疫类型:
--
- 细胞形态:
淋巴细胞样
- 是否是肿瘤细胞:
是
- 器官来源:
脾脏
- 运输方式:
复苏发货或干冰冷冻发货
- 年限:
--
- 生长状态:
悬浮
- 规格:
T25
以上产品图片均为本公司细胞出入库时拍摄
培养条件:
培养基:DMEM,10%FBS,SP;
气相:空气95%,二氧化碳5%;
温度:37℃培养
RCB参考图片:
描述:该系是由BALB/c脾脏细胞(取自绵羊红细胞免疫小鼠)与P3X63Ag8骨髓瘤融合而成。不分泌免疫球蛋白,对20μg/ml 8-氮鸟嘌呤有抗性,对HAT敏感。 检测发现鼠痘病毒阴性
收到货后处理方式: 1.细胞冻存管: 收到货物后,请检查箱子里面是否还有干冰。 ● 若干冰已剩余不多,不能掩埋冻存管,请及时拍照,并第一时间联系销售。 ● 若干冰充裕,可以安排复苏细胞,复苏方法参考【说明书】;不安排复苏,请将细胞冻存管转移到液氮进行保存。短期(一周内)的存放可以放在-80冰箱,建议最好保存在液氮中。 2.培养瓶的活细胞: 收到请检查培养瓶是否完好,是否有漏液,培养基是否浑浊 ●若出现以上问题请于当天和我们销售取得联系,我们会第一时间为您处理。 ● 若以上问题都没有出现:拆掉培养瓶的外包装,在显微镜下对细胞进行多个视野,不同倍镜拍照。然后用酒精对瓶身进行彻底消毒,放在37度二氧化碳培养箱中进行复温。1-2小时后,拿出在显微镜下观察,并进行多个视野不同倍镜拍照。若细胞达到了可以传代的密度,请按照【说明书】的传代方法进行操作。若细胞密度不能进行传代,请回收培养瓶中的培养基,留适量培养基在瓶中,并将培养瓶放在培养箱继续培养即可(个别细胞除外,详见说明书)
仅供研究之用
联系我们:
风险提示:丁香通仅作为第三方平台,为商家信息发布提供平台空间。用户咨询产品时请注意保护个人信息及财产安全,合理判断,谨慎选购商品,商家和用户对交易行为负责。对于医疗器械类产品,请先查证核实企业经营资质和医疗器械产品注册证情况。
- 作者
- 内容
- 询问日期
文献和实验率及所产生的杂交瘤细胞系的稳定性等方面均可与PS-X63-Ag8或P3-NS1/1-Ag4-1相比拟。 4.小鼠P3-X63-Ag8-U1(1980年Sharon)。是P3-X63-Ag8骨髓瘤细胞系的变系。P3-X63-Ag8分泌重链(rl)和轻链(K),P3-NS1/1-Ag4-1则只合成而不分泌轻链(K)。 5.小鼠SP2/O-Ag14(1978年Shulman)。Kohler等将PS-X63-Ag8骨髓瘤细胞系与具有抗绵羊红细胞活性、产生r2b重链和K轻链的BALB/c小鼠
鸟嘌呤 - - SP2/0-Ag14(SP2/0) ( X63 × BALB/C 脾细胞)杂交瘤 8- 氮
0―Ag14(简称SP2);③P2―X? ―Ag8・6・5・3(简称653);④FO以653最为常用,它是由矿物油4-甲基-15烷(Pristane,降植烷)诱发出来的一种浆细胞瘤(Minerol Oil plasmacy toma,MOPC)并经过培育形成一株8-氮鸟嘌呤有抵抗力的亚系。 骨髓瘤细胞一般由有关单位直接引入,保存于-195℃液氮罐中,试验时复苏、增殖、传代即可。由于骨髓瘤细胞是半贴壁状态,很容易脱落,因此不需要胰酶处理。为了防止出现返祖现象,在融合前,可将培养基内加入15μg/ml
技术资料暂无技术资料 索取技术资料

![FTC-133[ FTC133]人甲状腺癌细胞](https://img1.dxycdn.com/2020/1028/406/3596563422906234443-14.jpg!wh200)

![U-87 MG[U-87MG; U87 MG; U-87-MG; U87-MG; U87MG; U-87; U87; 87 MG; 87MG]脑星形胶质母细胞瘤](https://img1.dxycdn.com/2020/0412/951/3407350757447076141-14.jpg!wh200)
![OE33[OE-33; JROECL 33; JROECL33; OEC33]人食管腺癌细胞](https://img1.dxycdn.com/2020/0810/454/3507108789312169243-14.png!wh200)

